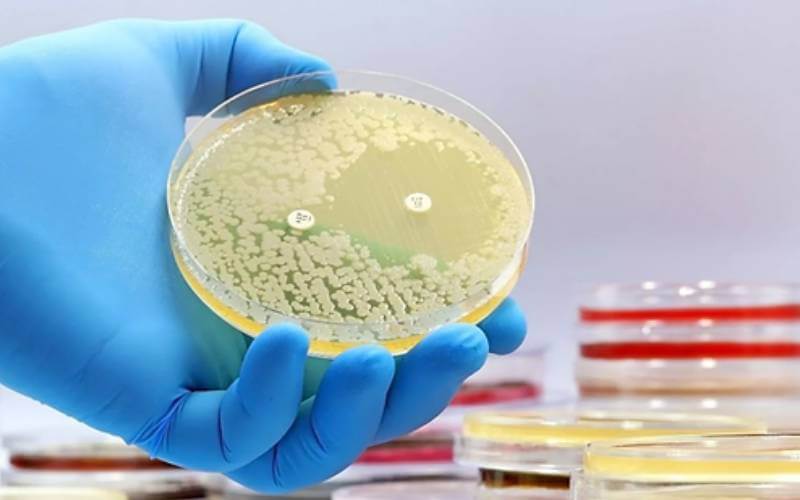
Portada

Imagen. / IIE
2024-02-28
Científicos descubren los primeros antibióticos nuevos en más de 60 años gracias a la IA
El uso de la inteligencia artificial (IA) está cambiando las reglas del juego en todos los ámbitos, pero también en el de la medicina, ya que esta tecnología está ayudando a los científicos a descubrir los primeros antibióticos nuevos en 60 años. El descubrimiento de un nuevo compuesto capaz de eliminar una bacteria farmacorresistente que mata a miles de personas cada año en todo el mundo podría suponer un punto de inflexión en la lucha contra la resistencia a los antibióticos.
"La idea era que podíamos ver lo que aprendían los modelos para predecir que ciertas moléculas serían buenos antibióticos", afirma en un comunicado James Collins, profesor de Ingeniería y Ciencias Médicas del Instituto Tecnológico de Massachusetts (MIT) y uno de los autores del estudio. "Nuestro trabajo proporciona un marco que, desde el punto de vista de la estructura química, ahorra tiempo, recursos y conocimientos mecánicos que no teníamos hasta la fecha".El estudio se publicó este jueves en Nature y es el resultado del trabajo realizado por un equipo de 21 investigadores.
Estudio para "abrir la caja negra"
El equipo responsable del proyecto utilizó un modelo de aprendizaje profundo para predecir la actividad y toxicidad del nuevo compuesto. El aprendizaje profundo consiste en el uso de redes neuronales artificiales para aprender y representar automáticamente características a partir de datos sin programación explícita. Se aplica cada vez más en el descubrimiento de fármacos para acelerar la identificación de posibles candidatos, predecir sus propiedades y optimizar el proceso de desarrollo de fármacos.
En este caso, los investigadores se centraron en el Staphylococcus aureus resistente a la meticilina (SARM). Las infecciones por SARM pueden causar desde infecciones cutáneas leves a afecciones más graves y potencialmente mortales, como la neumonía y las infecciones del torrente sanguíneo.
Según el Centro Europeo para la Prevención y el Control de las Enfermedades (ECDC), cada año se producen en la Unión Europea casi 150.000 infecciones por SARM y cerca de 35.000 personas mueren por infecciones resistentes a los antimicrobianos.
El equipo de investigadores del MIT entrenó un modelo de aprendizaje profundo
Para crear los datos de entrenamiento, se evaluaron aproximadamente 39.000 compuestos por su actividad antibiótica contra el SARM. Posteriormente, tanto los datos resultantes como los detalles relativos a las estructuras químicas de los compuestos se introdujeron en el modelo.
"Lo que nos propusimos en este estudio fue abrir la caja negra. Estos modelos constan de un gran número de cálculos que imitan las conexiones neuronales, y nadie sabe realmente lo que ocurre bajo el capó", explica Felix Wong, postdoctorando en el MIT y Harvard y uno de los autores principales del estudio.
Descubrir un nuevo compuesto
Para optimizar la selección de posibles fármacos, los investigadores emplearon otros tres modelos de aprendizaje profundo. Estos modelos fueron entrenados para evaluar la toxicidad de los compuestos en tres tipos distintos de células humanas. Al integrar estas predicciones de toxicidad con la actividad antimicrobiana determinada previamente, los investigadores identificaron compuestos capaces de combatir eficazmente los microbios con un daño mínimo para el cuerpo humano.
Utilizando este conjunto de modelos, se analizaron aproximadamente 12 millones de compuestos disponibles en el mercado. Los modelos identificaron compuestos de cinco clases diferentes, clasificados en función de las subestructuras químicas específicas de las moléculas, que presentaban una actividad prevista contra el SARM.
Posteriormente, los investigadores adquirieron unos 280 de estos compuestos y los probaron contra el SARM en laboratorio. Este método les llevó a identificar dos prometedores antibióticos candidatos de la misma clase. En experimentos con dos modelos de ratón -uno de infección cutánea por SARM y otro de infección sistémica por SARM- cada uno de estos compuestos redujo la población de SARM en un factor de 10.
Instituto de la Ingeniería de España
El Instituto de la Ingeniería de España, creado en 1905, es una entidad sin ánimo de lucro declarada de Utilidad Pública, cuya presidencia de honor ostenta Su Majestad el Rey Felipe VI desde 2014. El Instituto de la Ingeniería de España integra a más de 100.000 ingenieros de las diversas especialidades, que desarrollan su actividad en las diversas Comunidades Autónomas del Estado, tanto en el ámbito privado como el público.